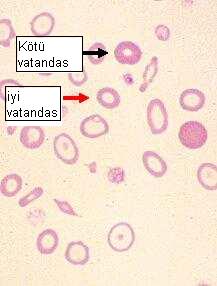

Yokluğum Türk varlığına armağan olsun
By Tavit Kilimciyan on Kas 14, 2008 in AKP, Basın günlüğü, Ermeniler
Milli Savunma Bakanı Vecdi Gönül soruyor: “Bugün eğer Ege’de Rumlar devam etseydi ve Türkiye’nin pek çok yerinde Ermeniler devam etseydi, bugün acaba aynı milli devlet olabilir miydi?”
Soru basit, hadi cevap ver.
Tek başına bir anlamı yok tabii. Hatta tek başına okunsa “Allah söyletmiş” ya da “gönülden söylenmiş sözler” de denebilir. Nitekim dünyanın birçok yerinde “Türkiye etnik temizliği kabul etti”, “Türkiye’de resmî görüş değişiyor” gibi olumlu yorumlarla karşılayanlar da olmuş.
Oysa işin aslı öyle değil. Zira Bakan “bugünkü devlet”i olumlayarak soruyor sorusunu. “Şunlar devam etseydi bugünkü devlet olur muydu” derken de eğer bugünkü devleti olumluyorsan, o devam etmeyen şeylerin devam etmemesinden de memnunsun demektir. Açık açık da söylemiş zaten -ben niye bu kadar uğraşıyorsam?..
Birçok yabancı, “bir savunma bakanı niye bunlarla ilgileniyor” diye de sorabilir tabii. Türkiye’yi biraz bileni de “savunma”nın bu ülkede başka bir egemenin tekelinde olduğunu bildiğinden, savunma bakanının asıl işini yapamadığı için mecburen başka şeylerle (demografik yapı, ekonomi vs.) ilgilendiğini düşünebilirdi. Ama Türkiye’yi biraz daha tanısa, azınlıkların bu ülkede tam da bu alanda değerlendirildiğini bilecek, hatta eğitim kitaplarında azınlıklardan sadece Lise Milli Güvenlik Ders Kitabı’nda bahsedildiğini bilecek ve Bakan’ın bu ilgisine hiç şaşırmayacaktı. Kısacası, savunma bakanı işini yapıyor.
Ciddiyete davet edildiğimi duyar gibi oluyorum. O yüzden bundan sonrası çok ciddi olacak. Soru neydi?..
“Rumlar, Ermeniler (YAŞAMAYA) devam etseydi, bugün Türkiye aynı milli devlet olabilir miydi?”
“Hayır olmazdı.” Basit soruya basit cevap.
Sen kalk, yokluğuma övgü düz, sonra da o yokluğum üzerine bir ülkenin kurulduğunu ifade et, o ülkenin bugünkü halini makbul gör, ondan sonra da ‘olsalardı ne olurdu halimiz’ diye iç geçir. Kendi ayağına kurşun sıkmanın tarifi gibi bir şey. ‘Sana ne’ diyeceksiniz. Sıkmışsa sıkmış. O ayakla sizin birlikteliğinizi çoktan koparmadılar mı zaten? Gerçekten de işin bu bölümünden artık bana ne…
Tabii işin en acı tarafı, Bakan’ın söylediklerinin büyük bölümünün maalesef doğru olması. Peki, doğruysa doğru, sorun ne? Bakan doğruyu söylüyor ama doğruyu yanlış söylüyor. Yüreğimizin tavan aralarına, bodrum katlarına koyup, gittiğimiz her yere beraberimizde götürdüğümüz, kırılgan acılarla dolu sandıklarımızı oradan oraya savuruyor. Zar zor, ite kaka vardığımız “O dönem herkes çok acılar çekti” kavşağından, direksiyonu birden bire “iyi oldu” sokağına kırıyor. Olanları doğru söylüyor ama olanların doğru olduğunu da söylüyor.
Şu soruya hakkıyla cevap verelim şimdi…
“Hayır, aynı olmazdı. Süper olurdu.”
Sen ne diyorsun?
Bütün ülke üç noktaya birikmez, kırk küsur merkez olurdu. Yirmi, otuz yıllık fidan hayatlarımız değil, kadim bir orman gibi kültürümüz olurdu. Anasının doğduğu yerde doğabilirdi herkes, işte o zaman ülke, “memleket” olurdu.
Ben neler söylüyorum?
Hiçbir şey değişmese bile en azından o insanlar bugün yanımızda, bizimle yaşıyor olurdu. Hiçbir şey değişmese bile en azından sen bu ülkede savunma bakanı olmazdın. Olsan da böyle düşünmezdin. Düşünsen de böyle konuşacak cesaret bulamazdın. Konuşsan da ertesi gün hâlâ bakan olmazdın.
Bir daha bakalım, savunma bakanı neyi savunuyor?..
Olmamamızın iyi olduğunu savunuyor. Tehcir ve mübadelenin Türkiye için çok hayırlı olduğunu savunuyor. Bunca yıl söyleyip duracaksın ‘öyle bir niyet yoktu, bunlar savaş tedbiri’ falan filan diye; ondan sonra da, bu “gönülsüz tedbirler”den nasıl fayda sağladığını, onların üzerine nasıl inşa olduğunu falan, rahat rahat anlatacaksın.
Bu gönülsüz tedbirlerin anlamının “milyonlarca can” olduğunu ayrı bir cümlede söyleyeyim dedim, yoksa ağır olacak…
Çok sık unutulan ilginç bir şey söyleyeceğim: Biz hâlâ varız. İşte şu kadarız bu kadarız. Azız mazız, azınlığız, ama varız. Bizim de (yani şu an olanlarımızın da) olmamamızı mı istiyor Bakan?
“Yok” diyecek elbet. “Estağfurullah. Olur mu hiç öyle şey; sizin başımızın üstünde yeriniz var.” Madem bizim olmamızın bir mahzuru yok o ölenler, o gidenler de olsaydı… Ama o bunun cevabını vermiş. Onlar işte verimli topraktaydı, adadaydı modadaydı, paralar onlardaydı… “O verimli topraklar, o paralar babanın malıydı da hileyle hurdayla mı aldılar, yalanla dolanla mı aldılar? Onlar, o verimli topraklara gökten zembille mi indiler” diye sorarlar adama.
Bu resmî tez benim kafamı iyice karıştırdı. O insanlar tedbiren mi sürüldüler, yoksa verimli topraklardalar diye mi sürüldüler? Unutmuşum, zaten Ermeniler Ermeni oldukları için sürülmemişlerdi… Sadede geliyoruz galiba. Tabii o zaman “soykırım”dan yırtmak için verimli topraklardaki müslim-gayrimüslim herkes sürüldü” gibi bir şey söylemek gerekecek -o tarih de yakında yazılır herhalde.
Sermayenin “milli”leştirilmesiyle (hele böyle millileştirme) liberal ekonominin aynı cümlede nasıl kullanıldığını da bir uzman bize anlatır artık. Sen “milli”yi böyle tarif et, “millet”i, “Türk”ü böyle tarif et ondan sonra da çıkıp “tek millet” diye slogan attığında karşı çıkanlara kapıyı göster. “Ben Türk değilim” diyene de kız.
Çok ciddi bir önerim var. Hani göz bebeklerimizi, civcivlerimizi her pazartesi sabahı, torna-tesviye sıralarına oturtmadan önce, beton bahçelerde topluyoruz ya, hani onlara şuur aşılayıp, tekleştirip, kutsal amaçlara kanalize edip, dar borulardan geçiriyoruz ya. Hani hep bir ağızdan ant içtiriyoruz ya: “Varlığım Türk varlığına armağan olsun” diye… Azınlık okullarında şöyle dedirtelim çocuklara mesele kapansın: “Yokluğum Türk varlığına armağan olsun.”
İnkârdan ikrara doğru yol alınacağını elbette öngörebilirdik de, o ikrarın böyle gönülden bir ikrar, yaşananı olumlayan bir ikrar olacağını da doğrusu tahmin edemezdik.
“Gönülsüz tedbirler”den, “gönüllü yokluğumuz”a, resmî ağzın önlenemez evrimine tanık oluyoruz. İç ses artık işkembede durmuyor, duramıyor. Ne de olsa egemenler inkârı sevmez. “Madem egemenim, niye inkâr edeyim?” Egemenlerin “İnkâr Hanı”nda konaklamaları geçicidir hep; o, hanın jeopolitik önemindendir, konjonktür baskısındandır, meşruiyet derdindendir. Zincirinden boşaldı mı “İkrar Evi”ne dönmek ister, evi gibi yoktur onun. Gönlünde yatan aslan kükrer: Yaptımsa yaptım; yine yaparım!
Sür kardeşim o zaman. Gönlümüz zaten sürüldü çoktan. İliklerimize işlemiş kör olası ilkeler sayesinde zaten zar zor durduğumuz memleketimizden, atalarımızın, daha da önemlisi torunlarımızın yüzüne bakacak onurlu bir duruş uğruna ağız dolusu lafı yiyip yuttuğumuz, her gün yaşamaya çalışarak yaşadığımız DÜNYAMIZDAN, sür bizi de gayrı. Sür gitsin, sür bitsin. Bu lafı yutmayacağım ben.
Ama niye süreceksin? Bizim etimiz ne budumuz ne? Dişinin kovuğuna gitmez. Zaten biz sürüyüz. Egemenliğe ortak olmayı istemek yerine, egemenin akıllısını ister ya sürüler, bizimki de o misal; oturmuş egemenin akılsızlığından bahsedip, egemen uyarıyoruz. Bu kadarı da fazla, bu iş böyle göstere göstere de yapılmaz ki. Vicdan evinden hiç mi geçmedi yolun?

10 Yorum
Yazan:zorbek acem Tarih: Kas 14, 2008 | Reply
öncelikle baştan sona yapılan yapılan bir yanlışı dile getireyim. tarih bir bilimdalıdır ve objektif esaslara dayanır. tarih üzerine şöyle olsaydı ne olurdu böyle olsaydı ne olurdu diye konuşulamaz konuşulduğu zaman kıraathane muhabbetine döner tarih dediğimiz olgu. tarih bir manada geçmiş, sonradan yaşanılan zamanda sonradan oluşturduğu etkiler göz önüne alınarak yorumlanamaz. bilimsel olarak bu duruma derler tarihi şimdiki duruma göre yorumlama manasına gelir. tarih içinde bulunulan zamana göre o zamanın koşullarına göre değerlendirilir.
yazıyı yazan arkadaş ermeni, ha şunu da belirteyim ben kumkapıda büyüdüm apartmanımızda 4 ermeni aile komşumuz vardı. ermeni çok arkadaşım vardı. bu yüzden içimde ermenilere karşı hiç bir zaman nefret hissedemedim.evet yazıyı yazan arkadaş ermeni ve yazarken de türk milletinin her zaman güçsüzden yana olma alışkanlığından faydalanmış biraz ajite etmiş durumu. tarihi bildiği kesin bu konuda şüphem yok fakat yazarken hisleri aklının önüne geçmiş. o da biliyor ki bu ülkede milleti sadıka olan ermenilerdir. avrupa hristiyanlığın bir kenar mahallede unutulan bu üvey çocuğunu hatırlyınca maalesef zamanın akımlarından fikirlerinden etkilene milleti sadıkamız özgürlük arayışına giriyor. bu arayışın önüne gelen herşeyi sürüp götürüyor. tabi devlet ve millet de bunu karşılıksız bırakmayarak tepki veriyor. tehcir, karşılıklı çatışmalar eşkiya baskınları malesef bu milletin ülkedeki varlığını azaltıyor. bu sonuç osmanlının yada türkiye cumhuriyetinin bir günahı değil zamanın ruhuna göre göstermesi gerektiği tepkilerdi.
şimdi gelipte ya işte bizim sayımızı azalttınız zaten çok azızı bizden ne istiyorsunuz başka yapacağınızı zaten yaptınız ya manasına gelen cümleler sarfetmek ciddi derece gereksiz.
ha bakanın sözüne gelince tabi talihsizlik ülkede bu konumda olan birinin konuştuklarının ne manaya geldiğini bilmeli kılı kırk yarıp konuşmalı. gırtlakta kır düğüm vardır derler söz her düğümden geçerken bir kez daha düşünmeli laf ağızdan çıkmadan önce sizin çıktıktan sonra ise siz onun esirisinizdir. bu arada bu talihsiz konuşmayı fırsat bilip zaten devlet böyle bu sözler devletin bilinç altında yatanın dışa vurumudur şekşinde yorumlamamak gerekir.
kalp kırmış ve sürçü lisan etmiş isem affola
sağlıcakla….
Yazan:özlem Tarih: Kas 14, 2008 | Reply
Peki sizin bahsettiginiz bu ‘tarihi gerceklerden’ Kayseri de oturan, Siirt te yasayan adama neydi de surulduler surulmeyi HAK ETTİLER. Peki yaziyi yazan Errmeni arkadasin babasinin ne gunahi vardi sokak ortasinda ensesinden kursunlanip olduruldu. Ve bu arkadasta tasi taragi toplayip bu ulkeyi terk etti. İnsanlar aci cekiyor ajitasyon yapmiyor bunu gormek bu kadar zor olmamali.
Yazan:Aziz Yılmaz Tarih: Kas 14, 2008 | Reply
Umarım talihsiz beyanlarda bulunan bakan bey bu yazıyı okur da bir parça kendisine gelir,insanlığından utanır.Ancak her şeye rağmen büyük bir çoğunluğun bu olay karşısında gerekli insani tepkiyi göstermesi,barış adına,kardeşçe birarada yaşama adına son derece umut verici bir gelişme.
Yazan:Mustafa Akbas Tarih: Kas 14, 2008 | Reply
hallo!! Lütfen biraz dikkat o kadar kolay degil insanlari biryere sürmek.Slobodan denilen Sirp’ da denedi insanlari sürmeye ve dizmeye adamin sonu malum. AK partililer Osmanliyla cok övünürler ama neden osmanlinin yüzyillarca Yunanlilari, Ermenileri ve baska Irklari baris altinda himayeleri yasatdilar biliyorlarmi? Osmanlida insanlar inanclarinda ve yasamlarinda hür’dü. Vergisini veren Krallar gibi yasardi ve gayri Müslüman osmanlida istikbal yapmistir. Bugünkü Türkiyemiz Osmanlilin bile gerisinde. Vesayet altinda girmis Hükümetin yetkisiz savunma bakanin irk ve insan düsmani konusmasini normal karsilamak lazim. Darbelenmis hükümetin barisa artik bir katsisi olamaz. TSK etnik sorunlari silah gücüyle cözmek isteyor ama maliyetini zavalli halk ödeyor.Amerika yapti savaslari ödetti paralari, bosalti bankalari..sonucu malum.Aynisini Türkiyemizde bekliyor…sonucta paralar ödenecek. Silahlar ve Golf Sahalari bedava degil. ok.. taman.. kisa tutayim. Gecmisiyle ugrasan, bugünü göremeyenin, yarini yoktur.
Yazan:zorbek acem Tarih: Kas 15, 2008 | Reply
özlem hanım öncelikle şöyle anlatayım, eğer vücudunuzdaki bir yara bakteri kapmışsa ve zamanında gerekli tedbirleri almayıp bu yarayı temizleyememişseniz son çare olarak size daha fazla zarar vermemesi için ne pahasına olursa olsun ne kadar acı verirse versin orayı keser atarsınız ki hayatınıza devam edebilesiniz. ve bu işlemi yaparkende şu bakteri suçlu bu bakteri suçsuz diye bir ayrıma gitmezsiniz.
ben her ermeninin türklere kurşun sıktığını söylemiyorum ama durumu zamanın ruhuna göre yorumlarsanız tehcirde böyle zararlı ermeni zararsız ermeni ayrımı beklemek çok lüks olacaktır. hata elbette yapılmıştır. ama bu hatalar ksıtlı hatalar değil eldeki imkansızlıkların tabii neticesi olmuştur.
evet şu an bazı yararlar elde etmek amacıyla insanlar dedelerinin çektiği sıkıntılardan nemalanmak istiyorlar. bu inkar edilemez.toprak talebi tazminat talebi bunların başında geliyor.
hrant dink den bahsetmek gerekirse de bu cinayet türkiye de gündemi değiştirme amaçlı bir yerlere mesaj gönderme amaçlı yapılan cinayet. size şunu tavsiye ederim. küçük resimle uğraşırken büyük resmi kaybetmeyin. yoksa ayrıntılarda boğulursunuz.
son olarak belki sizde ermenisiniz fakat bu tür olayları değerlendirirken duygusal davranılmamalı. duygusal davranma sadece sizin kininizi besler mantıklı konuşmanızı engeller. işte bu da zor olan.
kalp kırmış ve sürçü lisan etmiş isem affola
sağlıcakla….
Yazan:Hasan Tarih: Kas 16, 2008 | Reply
Yok olanlar, yok edilenler..
Ne yaman şeymiş “nation building”.. Building inşa etmek anlamına gelir İngilizcede.. Ancak geriye dönüp bakıyorum da.. Şu 18 yıllık kısa hayatımda hiç de öyle “neyşın” göremedim ben. En azından her ay Doğu’da birileri toprağa düştü. (PKK’lı ya da TSK’lı)
Bir millet inşası için Ermenilere, Rumlara, Yahudilere ve Kürtlere bu yapılanlar işe yaradıysa; nedir hala bu akan kan?
1930’lu yıllardaki Trakya Olayları nedir?
6-7 Eylül nedir?
PKK neden vardır?
Bu kan akıyorsa ve sekseninci yılını çoktan geçmiş bu cumhuriyette hala milliyet denen saçmalık insanın insanla olan ilişkisini böylesine kötü yönde etkileniyorsa neye yaramış bu “building”?
Neyi inşa etmiş ?
Bence buna “nation destroying” demek gerekiyor..
“Build” edilmiş şeyler su kaçırmamalı çünkü..
Sizin yaptığınız “building” onlarca yıldır kan kaçırıyor..
Yazan:burak Tarih: Kas 17, 2008 | Reply
A.Ü.Siyasal Bilgiler Fakültesi, TODAİE, ABD Güney California Üniversitesi Master-İngilizce-Mülki İdare Amiri, Vali-Kaymakam, Mülkiye Müfettişi, İçişleri Bakanlığı Özlük İşleri Genel Müdürü, Kocaeli Valisi, Emniyet Genel Müdürü, Ankara, İzmir Valisi, YÖK Kurucu Üyesi, İçişleri Bakanlığı Müsteşarı, Sayıştay Üyesi ve Başkanı, Avrupa ve Dünya Sayıştaylar Birliği Divan Başkanı, Dünya Sayıştaylar Birliği Teşkilatı Denetçisi -TBMM Başkanvekili-Evli, 3 Çocuk.
Akabinde sözlerinin nerelere gidebileceğini hiç düşünmeden böyle bir açıklama yapmak. Düşündürücü tabii. Acaba akp nereye gidiyor, neyi amaçlıyor bu insanlar, merak ediyorum.
Yazan:MY Tarih: Kas 17, 2008 | Reply
AKP’nin son günlerdeki milliyetçi çikisi koordinasyon ile yapiliyor. Belli bir amaci var. Kibris’ta Cemil çiçek ve Babacan, burada RTE, Vecdi gönûl, son gazinin cenazesindeki gövde gösterisi, vs, vs.
Bu kadar sey raslanti sonucu olmaz 🙂
Yazan:mehmet fatih koç Tarih: Nis 9, 2010 | Reply
Burada önemli olan ermenılerın ölmesı yada acı cekmesı konusu değil bence geneli kaçırıyorsunuz.Genel de mantık”Ya devlet başa ya kuzguın leşe ” oldugu için buna yöenlik kararlar alınır.Zaman olur “kalkar göç eyler avşar elleri” zaman olur binlerce ermeni göç ettirilir yada öldürülür.Hatta gerekirse bu ülke tutup kendı başbakanını asar ve ona anıt mezar yapar bazen de 30000 kişinin ölümümnden sorumlu iti köpeği beslemek zorunda kalır.Burda kim haklı kim haksızın kavgasına girmeyelım bence ölen ölmüş giden gitmiş ….
Yazan:özlem Tarih: Nis 10, 2010 | Reply
Bıçak gibi sözler:(